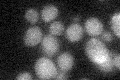

View description
Component of the Sin3p-Rpd3p histone deacetylase complex, involved in transcriptional repression and activation of diverse processes, including mating-type switching and meiosis; involved in the maintenance of chromosomal integrity
Localization:
Intensity:
Fold change:
Significance:
-
C’ GFP library in SD
below threshold16.09 -
N' NOP1pr-GFP in SD

nucleus74.7174 -
N' TEF2pr-mCherry in SD

nucleus29.9005 -
N' NATIVEpr-GFP in SD

nucleus36.4218 -
N' TEF2pr-VC and Cyto-VN in SD

nucleus35.3212 -
C’ GFP library in SD+DTT

cytosol13.870.86No -
C’ GFP library in SD+H2O2

cytosol19.491.21No -
C’ GFP library in Starvation Media

cytosol16.771.04No -
C’ GFP library on the background of Pup2-DaMP

below threshold -
C’ GFP library on the background of CCT mutant

below threshold16.68251.03626No
